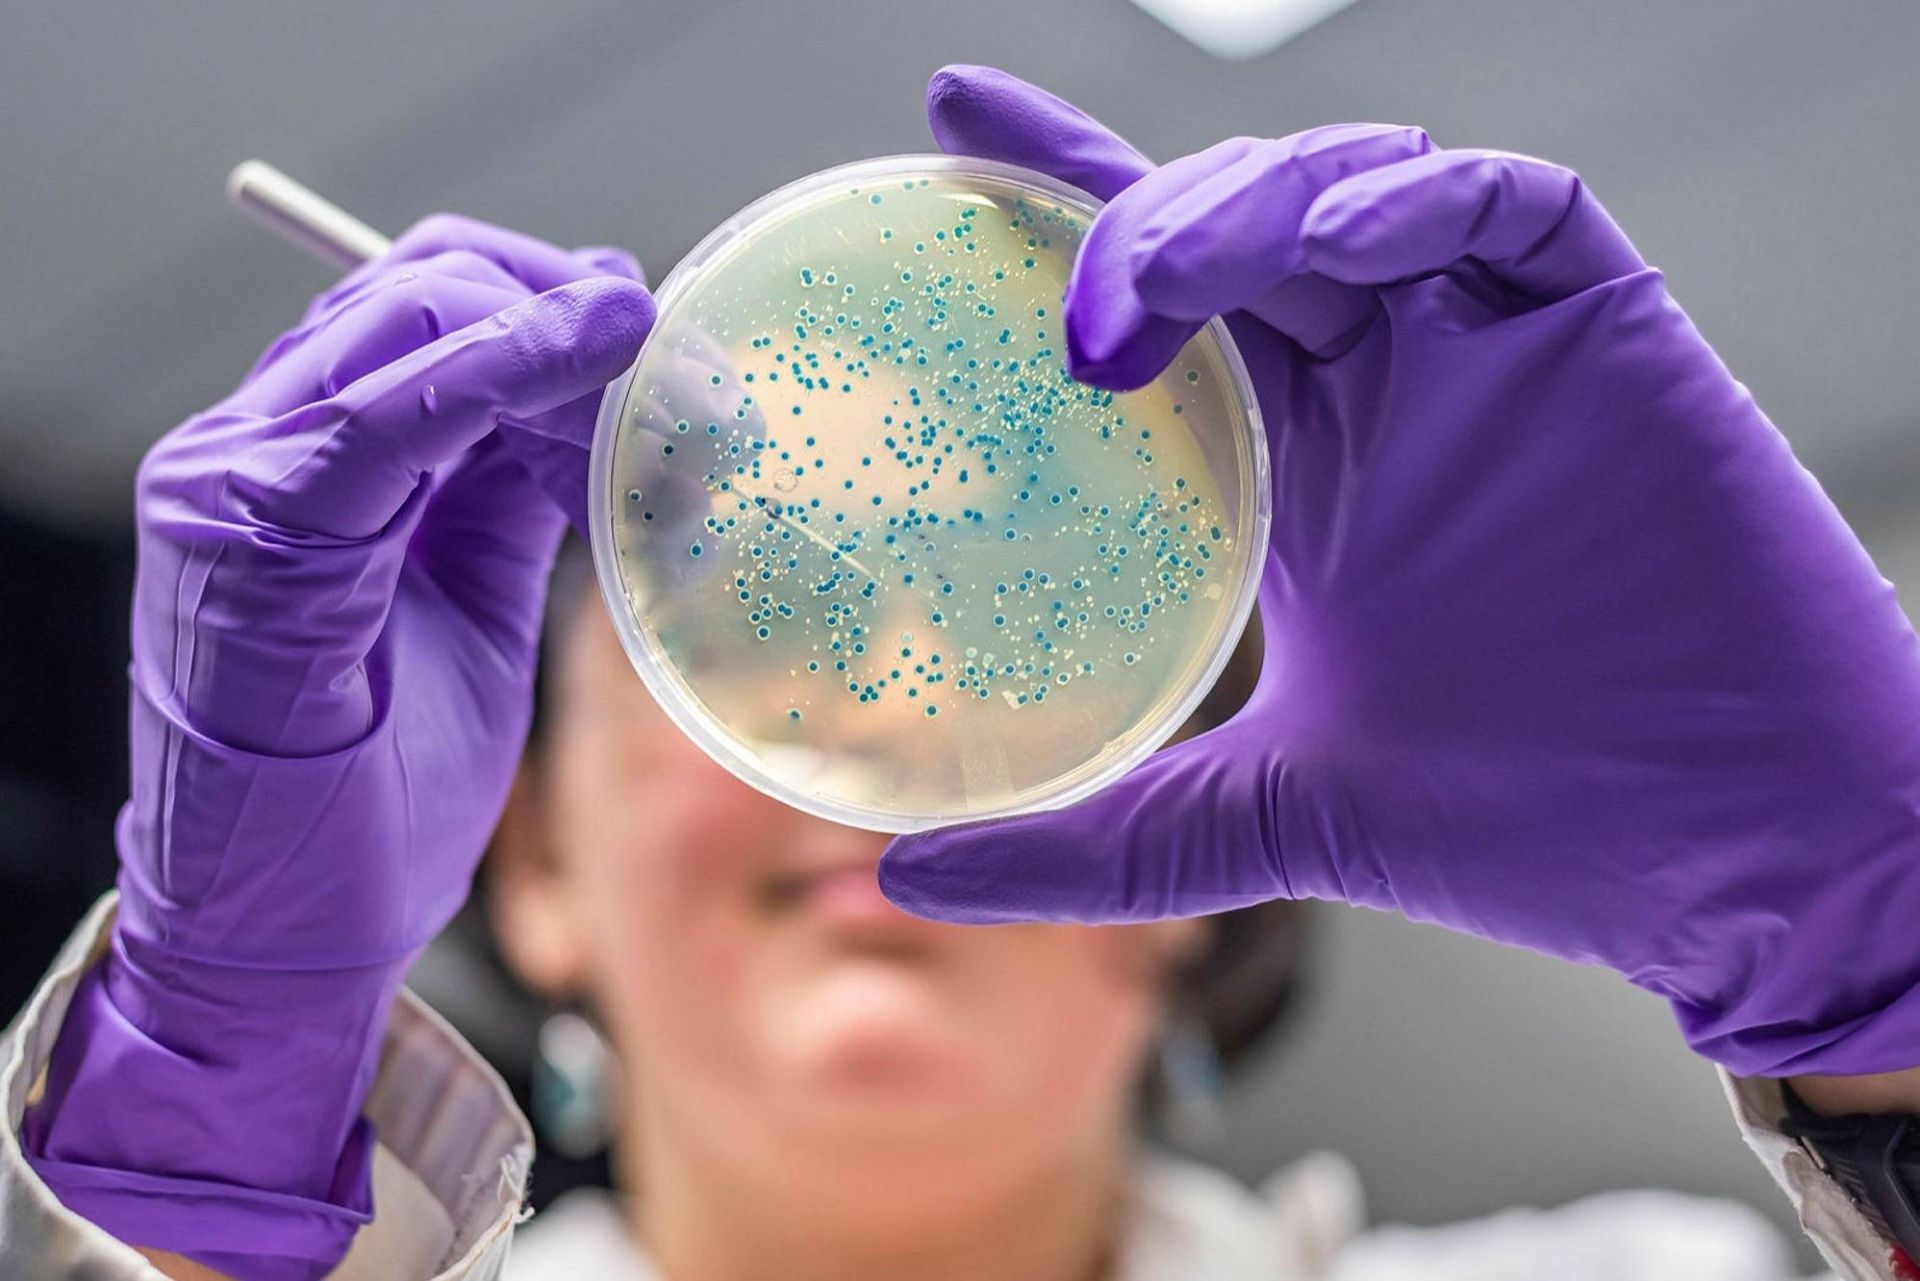

موفقیت ویروسهای باکتریخوار در درمان عفونتهای مقاوم به آنتیبیوتیک
خبر هیجانانگیزی در دنیای فاژدرمانی و مقاومت ضدمیکروبی وجود دارد. جری نیک از بیمارستان سلامت ملی یهودیان و گراهام هاتفول از دانشگاه پیتسبرگ درمان موفقیتآمیز بیمار دچار عفونت ریوی مایکوباکتریوم آبسسوس (Mycobacterium abscessus) را به کمک فاژدرمانی اعلام کردند. فاژها (باکتریوفاژها) ویروسهایی هستند که باکتریها را آلوده میکنند و میتوانند بدون نیاز به آنتیبیوتیکها آنها را از بین ببرند.
درحالیکه استفاده از فاژها به بیش از صد سال پیش بازمیگردد، با کشف و رونق آنتیبیوتیکها که جذابتر و سودآورتر بودند، آنها از رونق افتادند. اما ازآنجا که مقاومت آنتیبیوتیکی به مشکل رو به رشدی در سطح جهان تبدیل شده است، توجه به فاژدرمانی دوباره جان گرفته است.
فقط در ایالات متحده، سالانه بیش از ۲٫۸ میلیون عفونت مقاوم به آنتیبیوتیک اتفاق میافتد که ۳۵ هزار مورد مرگ را در پی دارد. سازمان جهانی بهداشت، مقاومت ضدمیکروبی را بهعنوان یکی از ده تهدید بزرگ بهداشت جهانی تعیین کرده است.
عدم سرمایهگذاری برای تولید دارو در این بخش مشکل موجود را تشدید کرده است، زیرا شرکتهای دارویی پژوهش روی آنتیبیوتیکها را کنار میگذارند و روی پیدا کردن داروهای سودآورتر برای بیماریهای مزمن یا داروهای سبک زندگی کار میکنند.
مایکوباکتریوم آبسسوس نوعی باکتری بسیار دشوار ازنظر درمان است که با توبرکلوزیس در ارتباط است. عفونتهای ریه با وجود استفاده طولانیمدت از آنتیبیوتیکهای سمی غالباً کشنده هستند.
اولین درمان موفقیتآمیز عفونت مایکوباکتریوم آبسسوس با استفاده از فاژها در سال ۲۰۱۹ اتفاق افتاد. در آن زمان، ایزابل کارنل هولداوی، نوجوان ۱۷ ساله مبتلا به فیبروز سیستیک پس از اینکه ریه پیوندیاش عفونی شد، با فاژ اصلاحشده ازنظر ژنتیکی تحت درمان قرار گرفت و تا چند سال پس از آن زندگی کرد.
در مورد فعلی، جارود جانسون، جوان ۲۶ ساله مبتلا به فیبروز سیستیک، دچار عفونتهای ریوی مزمن سودوموناس آئروژینوزا مقاوم به چند دارو و استافیلوکوک اورئوس مقاوم به متیسیلین بود. او سپس به عفونت مایکوباکتریوم آبسسوس دچار شد که مانع از پیوند ریه شد. مشکل جارود شبیه مشکلی است که بیماری به نام مالوری اسمیت با آن روبهرو شد، اگرچه عفونت مالوری ناشی از عفونت بسیار مقاوم بورخولدریا بود.
مراکز پیوند معمولاً بیماران مبتلا به عفونتهای باکتریایی مقاوم به چند دارو را برای انجام عمل پیوند که آخرین گزینه بیمار است، رد میکنند.
جانسون علاوه بر مصرف آنتیبیوتیک به مدت ۵۰۰ روز، تحت فاژدرمانی نیز قرار گرفت. در عرض دو ماه، آثار مختلفی دیده شد که حاکی از آن بود که درمان مؤثر بوده است و پس از یک سال بهنظر میرسید عفونت جانسون به کلی از بین رفته است. او پیوند ریه مضاعف (پیوند هر دو ریه) دریافت کرد و تا زمان بهبودی تحت فاژدرمانی قرار داشت.
جانسون اکنون تحت درمان نیست و شرایط خوبی دارد و توانسته است زندگی عادی خود را از سر بگیرد. همانطورکه هاتفول توضیح داد: «بیماران مبتلا به فیبروز سیستیک بهشدت به پیوند ریه نیاز دارند. عفونت مایکوباکتریوم نهتنها بد بود، بلکه مانع از دریافت پیوند در جانسون شده بود.» پس از گذشت بیش از یک سال از فاژدرمانی، تست خلط او منفی بود (باکتری رشد نکرد) و او توانست پیوند مضاعف ریه دریافت کند.
هاتفول همچنین اخیراً بیمار دارای نقص ایمنی را شرح داده است که دچار عفونت پوستی شایع مایکوباکتریوم کلونا بود و بسیاری از تلاشهای درمانی برای مبارزه با عفونت او با شکست روبهرو شده بود. این بیمار نیز با افزودهشدن فاژ به رژیم درمانی با موفقیت درمان شد. پزشکان مجبور بودند از فاژی به نام Muddy استفاده کنند، زیرا فاژهای دیگر دربرابر مایکوباکتریوم او فعال نبودند.
طبق توضیح هاتفول، یکی از مشکلات فاژدرمانی این است که برخی بیماران دربرابر فاژها واکنش ایمنی نشان میدهند که در خنثیکردن فاژها بسیار قوی است. اما درحالیکه بیمار دوم آنتیبادیهای خنثیکننده را تولید کرد، بهبودهایی را نیز نشان داد. هاتفول گفت:
این یکی از جنبههای برجسته این گزارش است. ما فقط از یک فاژ استفاده کردیم و هیچگونه مقاومتی تشخیص ندادیم. این نتایج همچنین نشان میدهد که برخی از فرضیات ما درمورد نحوه انجام این رویکرد احتمالاً نادرست بوده است. این فرض که ما به استفاده از فاژهای متعدد برای عفونتهای مایکوباکتریوم نیاز داریم، اشتباه بود. به همین دلیل است که فکر میکنم این نوع مطالعات موردی میتواند بسیار آموزنده باشد.
هاتفول افزود که او نمیگوید فاژها جایگزین آنتیبیوتیکها خواهند شد. اما آنها را بهعنوان ابزار ارزشمند جدیدی میبیند که درحال اضافهشدن به تجهیزات ما هستند. فاژدرمانی در برخی بیماران موفق نبوده است. او خاطرنشان کرد که این بیماران ازنظر کسب دانش بیشتر درمورد استفاده از فاژها بسیار مهم هستند. بهگفتهی هاتفول، وقتی این نوع درمان مؤثر باشد، هم برای بیمار و هم برای پزشکان، آسایش خاطر بزرگی نسبت به استفاده از آنتیوبیوتیکهای سمی برای مدت طولانی است.
هنوز نادانستههای زیادی درمورد فاژها بهعنوان درمانی برای عفونتهای مقاوم وجود دارد. درحالیکه فاژها میتوانند در درمان برخی عفونتها ارزش بسیاری داشته باشند، راهحل جادویی نیستند که بتوانند همه عفونتها را درمان کنند یا به کلی جایگزین آنتیبیوتیکها شوند. پژوهشگران میگویند برای انجام پژوهش بیشتر روی این رویکرد برای مبارره با مقاومت ضدمیکروبی به بودجه بیشتری نیاز است.